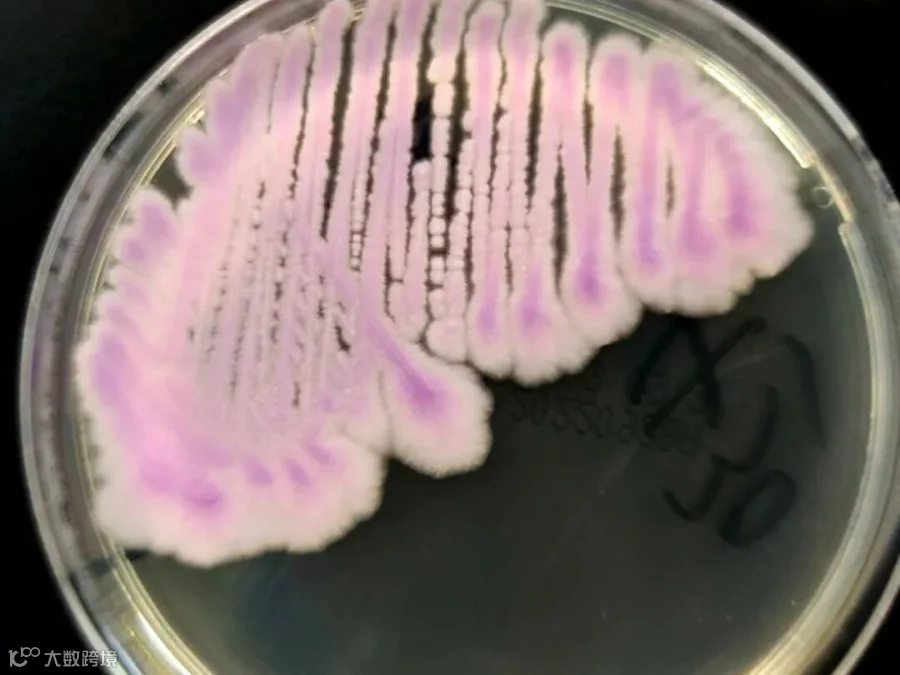

二、真菌DNA提取的难点
细胞壁结构复杂在营养生长阶段,绝大多数真菌会长出可分枝的丝状体,即菌丝。与动物细胞不同,真菌菌丝具有细胞壁结构,且相较于植物细胞壁,真菌细胞壁更厚,结构更为复杂。其主要成分包含纤维素、几丁质等多种复杂化合物,这种复杂的组成结构显著增加了 DNA 提取的难度。为实现细胞壁的充分溶解以释放 DNA,可采用液氮研磨的方法对真菌样本进行预处理;或者选用含有高效裂解酶的试剂盒,如捷倍斯生物(GBCBIO®-D7105)品牌的 Hpure Fungal DNA Kit 真菌 DNA 提取试剂盒,其中的裂解酶能够有效促进真菌细胞壁的溶解,最大程度地释放 DNA,能够从多种真菌的不同样品中提取DNA,特别适合于富含多糖多酚的真菌与真菌的样品。

核酸降解酶的影响:真菌细胞内存在多种核酸降解酶,当细胞破裂时,这些酶会迅速作用于 DNA,导致 DNA 降解,进而影响 DNA 的提取得率。因此,在提取过程中,除了使用无菌无酶的实验仪器外,还需优化实验流程,尽可能使各实验步骤紧密衔接,以最大程度地减少核酸降解。
样本杂质干扰:在真菌样本采集过程中,常混入其他微生物、植物残渣等杂质。这些杂质会干扰 DNA 提取的纯化过程,降低 DNA 提取质量。此外,真菌细胞富含多糖和色素等物质,这些成分容易与 DNA 结合形成复合物,致使提取的 DNA 纯度和得率不理想。
三、 真菌DNA的提取方法
物理破壁辅助法
加热裂解法:向上述备用菌中加100 μL DNA专用提取液,振荡混匀,100℃金属浴10 min,4℃ 12 000×g离心5 min,取全部上清液于–20℃保存备用。
微波法:向上述备用菌中加入200 μL DNA专用提取液,振荡混匀,微波高火30 s,连续4次,4℃ 12 000×g离心5 min,取上清液于–20℃保存备用。
反复冻融法:向上述备用菌中加入1 mL的无菌等渗氯化钠溶液,置–70℃冰箱中10 min,室温融化,重复冻融3次。4℃ 12 000×g离心10 min后去上清液,加入100 μL DNA专用提取液振荡混匀,金属浴加热5 min,4℃ 12 000×g离心5 min,取上清液于–20℃保存备用。
经典化学提取法
溶壁酶法:上述备用菌中加500 μL普通DNA裂解液(10 mmol/L Tris–HCl pH 8.0,10 mmol/L NaCl,pH 8.0的50 mmol/L EDTA),加溶壁酶(50 mg/mL)10 μL,水浴2 h后。加入等体积苯酚–氯仿–异丙醇(25∶24∶1),轻轻颠倒混淆1 min,4℃ 12 000×g离心5 min。吸取上清液,用等体积氯仿–异丙醇(24∶1)再抽提1次,4℃ 12 000×g离心5 min;取上清液加入2倍体积无水乙醇,–20℃冰箱静置30 min,4℃ 12 000×g离心5 min,弃上清液,加入200 μL 70%乙醇洗涤,4℃ 12 000×g离心5 min,弃上清液,扣干,加入50 μL Tris–EDTA缓冲液中充分溶解,所提DNA溶液于–20℃保存备用。
蜗牛酶法:蜗牛酶过夜处理法,上述备用菌中加500 μL普通DNA裂解液,蜗牛酶(10 mg/mL)100 μL和100 μL 1% SDS,37℃消化14 h,按上述酚氯仿法抽提纯化。
试剂盒抽提法
硅胶膜吸附法试剂盒:捷倍斯生物(GBCBIO®-D2605)Fungal DNA Kit 真菌DNA提取试剂盒,采用简便的硅胶柱结合纯化方式和独特的溶液处理系统,可处理多个100mg新鲜或30mg干燥真菌组织样品。独特的缓冲液与硅胶柱有效的去除组织裂解物种的多糖,酚类,以及酶抑制物,提取产物DNA可以用于 PCR,Southern杂交,酶切消化等实验。无需使用酚氯仿等有机,可以同时进行多个样品的处理。
磁珠法试剂盒:捷倍斯生物(GBCBIO®-M2605)MagIso Fungal DNA Isolation Kit 是专门为华大制造、KingFisher, 达安、天隆等核酸提取仪设计的产品,适合于从真菌样品中提取核酸。试剂盒基于超顺磁性的磁性粒子纯化技术,可最大程度减少交叉污染的风险,提高检测的灵敏度和准确度。仪器运行时间只需50分钟。得到的DNA可直接用于定量PCR和二代测序等实验。
原理:磁珠特异性吸附DNA,磁场分离。
适用:临床样本(如痰液中的念珠菌)、环境真菌群落。
四、真菌DNA提取试剂盒怎么选?
真菌DNA提取浓度
真菌 DNA 提取浓度是衡量提取试剂盒质量的重要指标之一,也是研究者重点关注的实验结果。
真菌DNA提取纯度
除提取浓度外,真菌 DNA 提取纯度也是评估提取试剂质量的关键指标。通常采用 OD260/OD280 的比值来衡量 DNA 纯度,理想情况下,该比值应介于 1.7 - 1.9 之间。
五、真菌DNA提取特殊样本优化方案
| 样本类型 | 挑战 | 解决方案 |
|---|---|---|
| 担子菌(蘑菇) |
|
|
| 病原真菌(如白念珠菌) |
|
|
| 环境样本(土壤真菌) |
|
|
六、真菌DNA提取注意事项
破壁优先级:
酵母:酶解(蜗牛酶/Zymolyase)> 机械破壁。
丝状真菌:液氮研磨 > 酶解。
抑制物去除:
多糖:CTAB结合高盐(1.4 M NaCl)或试剂盒去多糖模块。
黑色素:添加1%活性炭吸附(适用于暗色孢科真菌)。
DNA保存:
长期保存用TE缓冲液(pH 8.0),-80℃避光存放。
七、真菌DNA提取方法选择指南
| 场景 | 推荐方法 | 预期得率 |
|---|---|---|
| 基础研究(少量样本) |
|
|
| 临床诊断/高通量 |
|
|
| 宏基因组研究 |
|
|
| 顽固样本(如灵芝) |
|
|
八、真菌DNA提取常用酶解试剂
溶壁酶(Lywallzyme):广谱裂解真菌细胞壁(终浓度10 mg/mL)。
裂解酶(Lyticase):针对酵母β-葡聚糖(终浓度1 U/μL)。
几丁质酶:特异性降解几丁质(适用于毛霉等)。
品牌优势
捷倍斯生物可以提供专业和完善的核酸分离纯化解决方案,有硅胶柱法、磁珠法与溶液直接法的核酸纯化产品,在二代测序的样品前处理方面有着专业的技术与积累,有完善的针对唾液、血液与血浆等样品的保存、运输与高通量核酸纯化等整套的解决方案。 在诊断试剂原料方面,捷倍斯生物可以提供生物染色剂、高端的表面活性剂、显色底物、生物缓冲剂以及酶制剂与其稳定剂等系列产品。

做值交往的人|做值得信赖的产品



